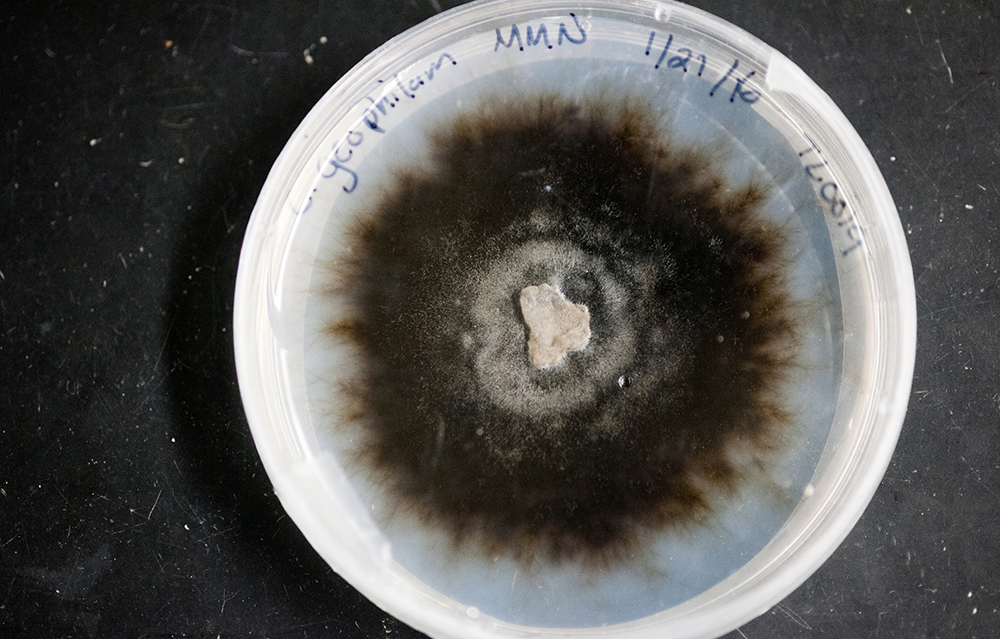

Why Fungi Rule the World
Jennifer Talbot studies the surprising role that molds, mushrooms, and other dirt-dwellers play in climate change
Mushroom hunting with biologist Jennifer Talbot
Walking through the woods with Jennifer Talbot (CAS’04) means seeing the forest with fresh eyes. But not the way you might think. Those tall, trembling pines stretching into the azure sky? Meh. The autumn sunlight dappling the canopy? Whatever.
The stick stippled with brown and white rot?
“Oh, YEAH!” shouts Talbot, stooping to grab the crumbly branch from the forest floor. She points to a cluster of gelatinous yellow blobs on the bark—a fungus called witches’ butter. “We used to think this was a slime mold, but it isn’t,” she says, pausing to admire the goo. “It’s actually edible, if you want to go there.”
For Talbot, all the action is underfoot. The assistant professor of biology studies a group of organisms called mycorrhizal fungi, which infect the root tips of over 90 percent of plant families on earth—in a good way. The fungi supply nutrients to the plants and get food in return. “The vast majority of plants you see outside could not live where they do without mycorrhizal fungi in the soil,” says Talbot.

Mycorrhizal fungi also have an outsize role in the decomposition of dead plants and the release of carbon. And since Earth’s soil contains more than three times as much carbon as its atmosphere, what fungi do in the soil could dramatically affect climate change. But nobody knows exactly how, and climate models are woefully fungus-free. Talbot, trained in analytical chemistry and working in biology, is particularly well positioned to fill this knowledge gap, and she’s using genetic sequencing, computer modeling, and ecosystem measurements to uncover fungi’s role. Kathleen Treseder, a professor of ecology and evolutionary biology at the University of California, Irvine, and Talbot’s PhD advisor, says Talbot is “doing stuff that no one else can do.”
One conclusion: humans have underestimated the humble fungi. Not Talbot. As she puts it, “Mycorrhizal fungi are running the world.”
Fungus: a love story

Fungi are not plants. But, like plants, they have their own kingdom, which encompasses an estimated 6 million species, including molds and yeasts. And while many people associate fungi with mushrooms alone, those familiar stems and caps are merely the fruit body, like an apple on a tree. The “business end” of a mycorrhizal fungus, says Talbot, consists of hyphae, long strings of cells that snake through the soil looking for nutrients, water, and minerals to suck from the dirt and send back to the host plant. In exchange, the host plant gives sugar to the fungus. “It’s a classic type of symbiosis in nature,” says Talbot.
Fungi are a quirky group, both beautiful and bizarre. One of the largest organisms on earth is a fungus called Armillaria ostoyae, sprawling through 2,200 underground acres in Oregon. Another species, Ophiocordyceps unilateralis, commonly known as “zombie fungus,” infects insects’ brains, exploding their heads to release spores. Despite this marvelous diversity, Talbot admits that she was slow to embrace fungi’s charms. “I was really interested in plants. I thought they were driving the show,” she says. “I didn’t know about fungi—they just seemed gross.”
Beautiful & Bizarre
Fungi are not plants. But, like plants, they have their own kingdom, which encompasses an estimated 6 million species, including molds, yeasts, and mushrooms.

Talbot’s interest in plants sprouted from her mother, Kathy Talbot, who studied biology with a focus on botany. The elder Talbot regularly took her children on hikes near their Chelmsford, Massachusetts, home, teaching them to look at plants through the eyes of a scientist. “If we found an acorn, it wasn’t just, ‘Here’s an acorn,’” says Kathy Talbot. “We would always talk about ‘Why?’ Why is this here, what does it do?”
The younger Talbot came to Boston University as an undergraduate in 2000 planning to study biology, but she quickly fell in love with chemistry, which suited her personality. “It was mathematical,” she says. “It was problem solving. It made sense. And that’s why I loved it.” As an undergraduate, she applied her chemistry knowledge to plants, working in the lab of biologist Adrien Finzi, also a BU professor. She studied chemical compounds called tannins, which leach into the ground from leaf litter and affect how organic matter in the soil breaks down. Finzi, impressed with his student’s intensity, focus, and enthusiasm, gave Talbot a textbook, Biogeochemistry: An Analysis of Global Change, which explains the chemistry of the Earth’s surface. To laypeople, this may seem like, well, kind of a lame gift. But the book, originally published in 1997, sends scientists into fits of rapture. Finzi describes it as “an epic tale of global proportions written out in scientific language.” Talbot says simply, “The book changed my life.” She keeps a copy on a shelf in her office and vividly recalls the first time she studied the chart of the global carbon cycle—the movement of carbon from land to water to air. (It’s on page 359.)
“I was particularly interested in soil because it’s the largest pool of carbon on land,” she recalls. Plants inhale carbon from the atmosphere and, through photosynthesis, make sugars and other compounds. Then the plants die, and most of the carbon ends up in the soil. When organisms like soil fungi and microbes decompose dead plants, they convert this carbon into carbon dioxide gas, which can find its way back into the atmosphere. “One of the interesting things I noticed is that the amount of carbon coming out of soil is roughly 10 times larger annually than the amount of carbon coming out of human processes on land,” says Talbot. “So these pools, if they are perturbed even slightly, could have an enormous impact on the carbon cycle and on climate change.”
Fungi’s Impact on the Carbon Cycle
Soil is the largest pool of carbon on land, and soil fungi play a huge – but poorly understood–role in the carbon cycle. Here’s what we know.

What happens in the soil to either accelerate or impede climate change is still poorly understood, however. And perhaps the least-understood part of the soil is fungus. Scientists have studied fungi for centuries, but mostly in the context of medicine—think Penicillium—or food (vive le Roquefort!). When Talbot decided to pursue a PhD, Finzi encouraged her to contact Treseder. Talbot, with a heart still set on plants, was unsure about casting her lot with a fungal ecologist. But Treseder intrigued her: unlike most scientists studying fungi, she wants to understand their role in climate change. “I want to know how ecosystems slow down or accelerate climate change, by taking up or giving off greenhouse gases,” says Treseder. “Fungi are the organisms most important to adding greenhouse gases to the atmosphere, and we know next to nothing about them.”
When Talbot joined her lab in 2006, Treseder was still trying to answer basic questions about how soil fungi work in the environment. One big reason for the information gap, says Treseder, is the lack of chemists in her field—most scientists who study fungi are ecologists or biologists. “What Jenny’s doing that’s really important is looking at the actual chemical transformations that the fungi are doing in the soil, breaking down compounds into CO2 or smaller molecules,” she says. “Because she can look at those particular details, we can get a much better picture of what’s actually happening.”“Not many people with training in analytical chemistry are brave enough to completely change fields,” she adds. “It was really courageous of Jenny to move to something so different.”At Irvine, Talbot started reading about decomposition, carbon cycling, and climate change. “I read and I read and I read. I read wherever the literature took me,” she says. “And it took me to a group of organisms called mycorrhizal fungi.” Fungi, finally, had melted her heart.
Perhaps the least-understood part of the soil is fungus. Scientists have studied fungi for centuries, but mostly in the context of medicine or food.

Nightmare closet? Or gold mine?
Talbot opens a steel door and steps into the chill of a walk-in refrigerator. Metal shelves line the walls, stacked with hundreds of plastic petri dishes. They contain a gruesome assortment of yellow, brown, black, and white fungi, the stuff that makes you recoil in horror when you see it growing in your fruit bin. But one person’s nightmare closet is another’s scientific gold mine: this is Talbot’s culture collection, containing 216 species (and counting). Somewhere among the brown rot and Cryptococcus may be the clues to climate change.

“We’re the only lab in the world that has all of the decomposer fungi with sequenced genomes that are fully functional,” says Talbot, picking up a dish holding a revolting blob of something brown and fuzzy. The collection allows Talbot to study soil fungi deeply, from multiple vantage points: the big-picture view of an entire ecosystem, the interactions with microbes in a petri dish, and the molecular and genetic dynamics of decomposition.
One example: she and her lab supervisor, Maria Osuna Garcia, are collaborating with associate professor of biology Pamela Templer on her National Science Foundation–funded project at the Hubbard Brook Experimental Forest in New Hampshire to study how climate warming and increasing freeze-thaw cycles may affect fungi and the microbes that work with them.
“Our work complements each other,” says Templer. “I think of myself as an ecosystem ecologist understanding how plants, soils, and microbes interact with each other. With Jenny’s expertise in microbiology, we can dig deeper in our experiments to understand who’s in the microbial community and how they function, to better understand the role of bacteria and fungi under a changing climate.”
Talbot and Garcia took soil samples from the Hubbard Brook site, extracted and sequenced DNA from the soil fungi, and then compared it with databases “to see exactly what fungi were down there,” says Garcia. “We’re not just dealing with one or two mystery fungi, but potentially thousands of different species coming together to make a unique community. These communities could shift with impending climate change, and ultimately affect processes at the ecosystem scale.” The results so far, presented at the Ecological Society of America and the Mycological Society of America meetings in August 2016, are grim. Increased freezing and thawing in winter can damage or kill tree roots. When this happens, certain mycorrhizal fungi decline and surge in peculiar patterns, and more plant pathogens emerge. “We don’t know why,” says Talbot, whose work is also funded by the Department of Energy’s Joint Genome Institute Community Science Program and the Peter Paul fund at BU. “We need to start culturing these organisms and do laboratory experiments with them. That way, we can see how the organisms evolve over time and what kinds of activities they’re capable of.”
“I mean, is it OK if half the fungus die? Or do we need to start thinking about the conservation of forests for the stuff that’s underground, not just the plants and animals?”
Jennifer Talbot
Ultimately, says Talbot, she hopes the work will lead to a better understanding of climate change, and she is working with Daniel Segrè, a BU professor of biology, bioinformatics, and biomedical engineering, and Mike Dietze, a BU associate professor of earth and environment, to build more accurate climate models. Current models of carbon cycling on land, says Talbot, can’t accurately predict carbon cycling in the future. “When you project them out to 100 or 500 or 1,000 years, they all go in different directions,” she says. “They don’t have a good representation of a lot of the biology.”
Talbot is still immersed in the process of discovery. “We’re trying to understand the diversity, the metabolic and the taxonomic and the genetic diversity of fungi that are out there, because we still don’t know,” says Talbot. “I mean, is it okay if half the fungi die? Or do we need to start thinking about the conservation of forests for the stuff that’s underground, not just the plants and animals?”
Imagine: World Wildlife Fund brochures featuring Penicillium instead of pandas, white rot instead of right whales. “Someday!” laughs Talbot, eyes alight at the idea. “Someday.”

Comments & Discussion
Boston University moderates comments to facilitate an informed, substantive, civil conversation. Abusive, profane, self-promotional, misleading, incoherent or off-topic comments will be rejected. Moderators are staffed during regular business hours (EST) and can only accept comments written in English. Statistics or facts must include a citation or a link to the citation.